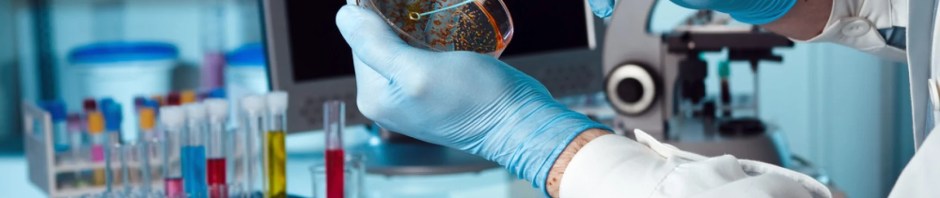

Si hay una rama de la ciencia que ha revolucionado la investigación científica del siglo XXI esa es la biotecnología, entendiendo como tal toda aplicación tecnológica que utilice sistemas biológicos y organismos vivos o sus derivados para la creación o modificación de productos o procesos para usos específicos. De hecho, la biotecnología (junto a la bioquímica y la biología molecular) es en la actualidad la primera disciplina en porcentaje de contribuciones científicas e impacto en el contexto internacional. Según se puede leer en el último informe de la Asociación Española de Bioempresas (ASEBIO), la biotecnología española representa el 3,2 % de la producción científica internacional en el área, siendo España la octava potencia a nivel mundial en publicaciones científicas biotecnológicas. La biotecnología española produce un 26 % de los artículos situados entre el 10 % más citados del mundo.
Para seguir leyendo este artículo, futón de mi colaboración con MUY INTERESANTE pinchen AQUÍ.

Jose

Estoy leyendo e intentando asimilar tantos datos que no sé si voy a volverme majareta. Lo que sí que percibo es que la biotecnología naranja para ti es pan comido.
Gracias por ser mi ‘Gurú’.